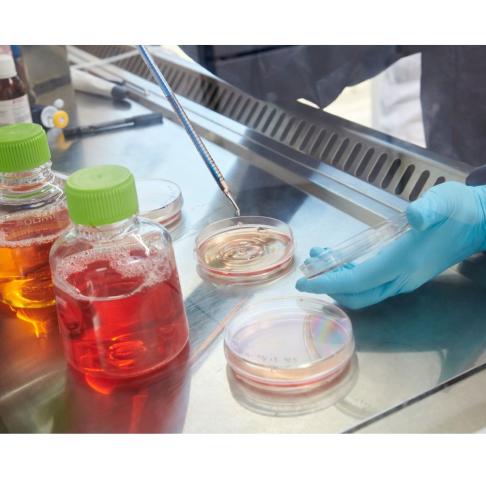

Plan de Relance
pftplus |
Le Plan de relance comporte trois plateformes d'Excellence
- supportées par la Wallonie, les plateformes d'Excellence BIOGREEN et SPACE
- supportée par la Fédération Wallonie-Bruxelles et l'Union Européenne, la Plateforme d'Excellence TRANSITION ENERGETIQUE
La plupart des équipements financés se retrouvent dans les plateformes technologiques de l'UCLouvain.